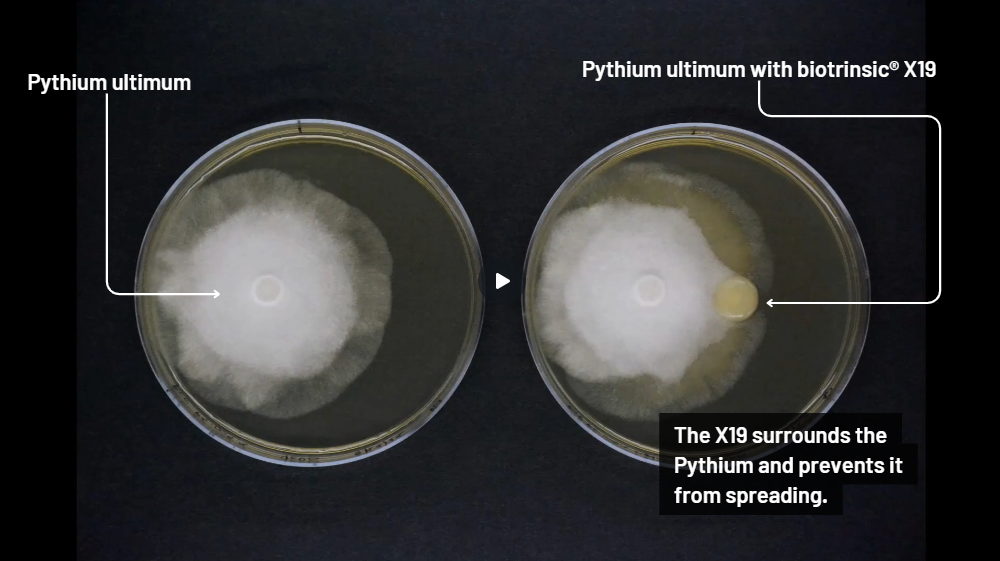
Pythium X19 Screenshot

biotrinsic® PathoShield™
Biofungicide for Corn and Soybean Crops
Main features
Proven Yield Boost
The corn results come from 46 field trials across 10 states during the 2022-2024 seasons and the soy data comes from 18 field trials across 8 states during the same period.
This means you’re getting recommendations that are tried and true, tested in different soils and conditions, so you know they’ll work when the rubber meets the row!
Disease Management
Designed to manage major seedling diseases in corn and soybeans, it effectively targets Fusarium, Pythium, and Rhizoctonia, ensuring a healthier start for your crops.
Ease of application
The Flowable Powder (FP) formulation is easy to apply directly to seed at planting, working seamlessly with any type of drill or planter.
Compatibility
Compatible with a broad range of pesticide treatments, it enhances and broadens the spectrum of disease control for more robust crop protection.
Flexibility of use
Suitable for both corn and soybeans, reducing the risk of over-purchasing or wasting unused product.
Seeing is believing
PathoShield (formerly X19) works like a boost to your crops' natural potential—driving longer, stronger roots, more consistent cob sizes, and helping soybeans hit the next growth stage faster, putting them ahead in the race compared to untreated fields.
See how these crops performed in the field. Hover over each case study to reveal the yield results.
How does it work?
Zooming in on Bioblocker™
When PathoShield (formerly X19) comes into contact with harmful fungi, it quickly spreads and grows along the fungal strands. As it moves, it releases a thick protective layer called a biofilm, which coats the fungus. This biofilm—made up of natural proteins and sugars—acts like a shield, stopping the fungus from reaching and infecting the plant. We call this defense mechanism Bioblocker™ Technology.
The two plates shown here illustrate how Bioblocker™ Technology works. Both plates contain the soilborne disease Pythium ultimum, but only one has PathoShield added. On that plate, you can see how PathoShield surrounds the pathogen, forming a strong barrier that keeps it from spreading.




Application Methods
Our FP products are designed with the needs of American farmers in mind, offering versatile application options to suit your planting operations. It can be applied directly to seed in individual row boxes, large hoppers on air-seeders, bulk seed boxes, or seed tenders. For added convenience, it’s also compatible with application devices while seed is conveyed through an auger or conveyor belt, ensuring efficient and even treatment. Whether you're managing small-scale plots or expansive fields, this adaptable solution helps optimize your planting process.
If you're located in one of the following states, you can purchase PathoShield directly from our online store for a seamless and convenient shopping experience.
Eligible States:
Alabama, Arkansas, Colorado, Delaware, Florida, Georgia, Illinois, Indiana, Iowa, Kansas, Kentucky, Louisiana, Maryland, Michigan, Minnesota, Mississippi, Missouri, Montana, Nebraska, New York, North Carolina, North Dakota, Ohio, Oklahoma, Pennsylvania, South Carolina, South Dakota, Tennessee, Texas, Virginia, West Virginia, Wisconsin, Wyoming
Shop now and enjoy the convenience of having PathoShield delivered straight to your door.
Unsure how much product you need? Try our calculator
How much PathoShield you need for corn
Results
You will need to purchase about pouch(es)
A unit equals 50 lbs of corn seed. For soybeans, one unit covers 140,000 seeds, which is typically enough for one acre. Use our calculator on the left to determine how much product you need.
Can't find your retailer or have another question?
Let us know in the form below. Please provide your email and phone number, so we can contact you regarding your query. Your state information helps us put you through to the right person.
Interested in other biotrinsic® products this season?
All data and statistics referenced were collected by Indigo or third parties, separately or jointly, from scientific studies in field or laboratory settings. Data presented may be limited to relevant subsets of all available data where appropriate in accordance with industry standards, such as subsets of fields that demonstrate applicable stressors. Indigo does not make any guarantees with respect to any outcomes of any Indigo product or service. A wide range of variables affect product performance, and your results and yields may vary. Additional terms, conditions and limitations may apply, including those stated on the product label. Product may not be available in all areas.